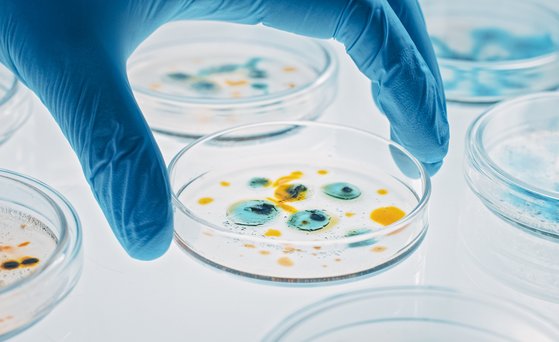
Hand trägt blauen Handschuh und hält Petrischle mit blau-gelber Kultur.

Forschung zur Mikrobiologie
Darum geht es
Aufgabe des BfRkurz fürBundesinstitut für Risikobewertung ist es, die Verbreitungswege von mikrobiellen Risiken in der Lebensmittelkette zu bekämpfen und das gesundheitliche Risiko belasteter Lebens- und Futtermittel zu bewerten. Die Bekämpfung von Erregern setzt dabei so früh wie möglich an: bei der Lebensmittelgewinnung und Herstellung.
Aufgabe
Mikroorganismen sind - abgesehen von Fehlernährung - die mit Abstand häufigste Ursache für lebensmittelbedingte Erkrankungen. Krankheitserreger können in Lebensmitteln, die vom Tier stammen, aber auch in pflanzlichen Lebensmitteln vorkommen.
Das BfRkurz fürBundesinstitut für Risikobewertung erforscht lebensmittelassoziierte Mikroorganismen, ihre Übertragungs- und Verbreitungswege sowie die Entwicklung von Diagnosemethoden, die für Routineuntersuchungen bei Lebensmitteln geeignet sind.
Am BfRkurz fürBundesinstitut für Risikobewertung sind daher auch mehrere Nationale Referenzlaboratorien (NRL) sowie weitere Speziallaboratorien und Laboratorien mit Referenzfunktion angesiedelt. Damit ist das BfRkurz fürBundesinstitut für Risikobewertung Teil eines EU-weiten Netzwerkes zur Verbesserung der Lebensmittelüberwachung.
- NRL für durch Lebensmittel übertragbare Viren
- NRL für Campylobacter
- NRL für Escherichia coli einschließlich verotoxinbildende E. coli
- NRL für Listeria monocytogenes
- NRL für Trichinella
- NRL für Antibiotikaresistenz
- NRL für Salmonella
- NRL für koagulasepositive Staphylokokken einschließlich Staphylococcus aureus
- Konsiliarlabor für Leptospiren
- Konsiliarlabor für Vibrionen
- Konsiliarlabor Yersinien
- Speziallabor für Sporenbildner
Themenbereiche
Stand: